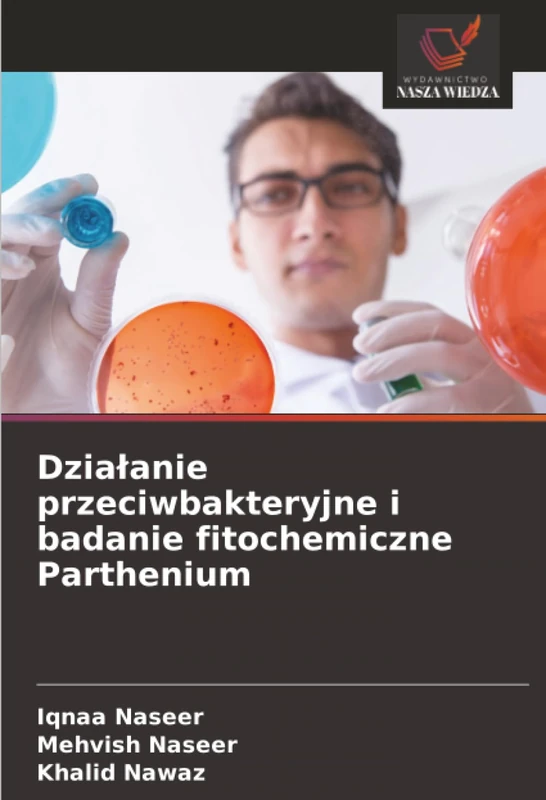
Działanie przeciwbakteryjne i badanie fitochemiczne Parthenium

We can't find the internet
Attempting to reconnect
Something went wrong!
Hang in there while we get back on track

£53.00
Synteza, aktywność przeciwutleniająca i przeciwdrobnoustrojowa nowych tiofenów: Związek przeciwdrobnoustrojowy i przeciwutleniający zawierający ... i przeciwutleniaj¿cy zawieraj¿cy tiofen
Price data last checked 21 day(s) ago - will refresh soon
Price History & Forecast
Last 70 days • 70 data points (No recent data available)
Price Distribution
Price distribution over 70 days • 1 price levels
Price Analysis
Most common price: £53 (70 days, 100.0%)
Price range: £53 - £53
Price levels: 1 different prices over 70 days
Product Specifications
- Format
- paperback
- ASIN
- 6208485479
- Domain
- Amazon UK
- Release Date
- 02 September 2025
- Listed Since
- 03 September 2025
Barcode
No barcode data available
Similar Products You Might Like

93% match
AktywnoŚĆ Przeciwbakteryjna I Przeciwgrzybicza Grzybów Endofitycznych
£54.00
08 Mar 2026

93% match
Odblokowanie naturalnych mechanizmów obronnych: Odkrywanie metabolitów przeciw biofilmom z ro¿lin leczniczych
£69.00
05 Mar 2026

93% match
SYNTEZA, WŁAŚCIWOŚCI I ZASTOSOWANIA ESTRÓW WINYLOWYCH KWASÓW KARBOKSYLOWYCH
£62.28
08 Mar 2026

93% match
Neuroprotekcyjne działanie kwercetyny: Fluorek sodu i kwercetyna
£80.00
12 Mar 2026

92% match
Badania właściwości przeciwutleniających niektórych rodzimych roślin: Poszukiwanie potencjalnych przeciwutleniaczy roślinnych
£42.00
12 Mar 2026

92% match
Synteza I Ocena Biologiczna Pochodnych Tiazolopirymidyny: Krótka analiza
£53.00
09 Feb 2026

92% match
Mikrobiologiczna synteza nanomateriałów Ti i rGO oraz ich zastosowania: Ekologiczna synteza nanomateriałów z dwutlenku tytanu i zredukowanego tlenku grafenu
£86.00
10 Mar 2026

92% match
Cytogenetyczny wpływ środków immunosupresyjnych
£62.00
08 Mar 2026

92% match
Nanonośniki zawierające aceklofenak: Produkcja i wybór substancji pomocniczej
£53.00
07 Mar 2026

92% match
STENTY PROTETYCZNE: OCHRONA PRZED PROMIENIOWANIEM
£53.00
16 Feb 2026

92% match
Fitozwiązki jako bezpieczniejsze środki przeciwbakteryjne
£48.00
07 Mar 2026

92% match
Ochronne dzialanie produktów z oliwek przed stresem oksydacyjnym: Wykorzystanie produktów z oliwek
£74.00
28 Feb 2026

92% match
TECHNOLOGIE CYFROWE W PROTETYCE: GDZIE TECHNOLOGIA SPOTYKA SIĘ Z ESTETYKĄ!!!
£61.00
08 Mar 2026

92% match
Środki przeciwdrobnoustrojowe w stomatologii: Antybiotyki i leki przeciwdrobnoustrojowe
£53.00
11 Mar 2026

92% match
Wzmocnienie składników aktywnych przez A. rhizogenes w Hyoscyamus muticus
£43.00
12 Mar 2026
92% match
Działanie przeciwbakteryjne i badanie fitochemiczne Parthenium
£54.00
19 Apr 2026

92% match
Toksyczność fluoru i zapalenie układu nerwowego
£76.00
01 Mar 2026

92% match
Biostymulanty w zrównoważonym rolnictwie i nauce o roślinach
£53.00
07 Mar 2026

92% match
Badanie ZwiĄzków Biologicznie Czynnych Poprzez Reakcje Katalityczne
£75.00
08 Mar 2026

92% match
OKREŚLANIE ZWIĄZKÓW ZABURZAJĄCYCH GOSPODARKĘ HORMONALNĄ W OBSZARZE RZEKI DŻUKSZEI
£59.00
03 Mar 2026

92% match
Nowe związki neuroaktywne wyizolowane z jadu osy społecznej: Bioprospekcja i neurobiologia
£53.00
08 Mar 2026

92% match
Rozklad celulozy przez promieniowce z Eisenia foetida
£54.00
08 Mar 2026

92% match
Synteza i badanie aromatycznych związków amidowo-estrowych
£48.00
07 Mar 2026

92% match
DOUSTNE OBJAWY I POWIKŁANIA CUKRZYCY: I JEGO ZARZĄDZANIE
£51.00
21 Feb 2026